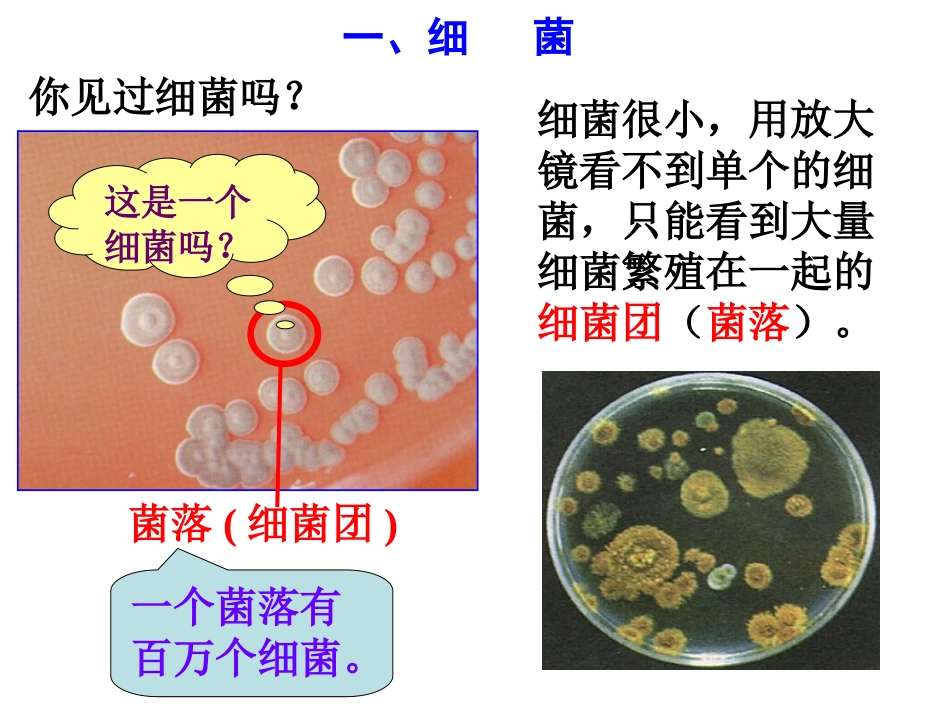
第6节细菌和真菌的繁殖（第一课时）_第3页

Copyright2004-2015版权所有盗版必究第一课时细菌Copyright2004-2015版权所有盗版必究请你说说,你所知道的有关细菌的知识
细菌很小;细菌有害处,使人得病;细菌使食物变味或发臭;细菌种类很多;变质的牛奶Copyright2004-2015版权所有盗版必究一、细菌你见过细菌吗
这是一个细菌吗
菌落(细菌团)一个菌落有百万个细菌
细菌很小,用放大镜看不到单个的细菌,只能看到大量细菌繁殖在一起的细菌团(菌落)
Copyright2004-2015版权所有盗版必究1、细菌的大小细菌是单细胞生物,个体很小
细菌一般要用高倍光学显微镜或电子显微镜才能观察清楚
Copyright2004-2015版权所有盗版必究葡萄球菌金黄葡萄球菌肺炎链球菌肺炎球菌球状显微镜下的各种细菌Copyright2004-2015版权所有盗版必究大肠杆菌枯草杆菌炭疽杆菌乳酸杆菌杆状显微镜下的各种细菌Copyright2004-2015版权所有盗版必究螺旋状螺旋菌霍乱弧菌显微镜下的各种细菌Copyright2004-2015版权所有盗版必究2、细菌的形态球菌螺旋菌杆菌Copyright2004-2015版权所有盗版必究3、细菌的结构细胞壁细胞膜细胞质无细胞核(有遗传物质)无成形细胞核的生物叫原核生物无叶绿体,无摄食结构,依赖现成的有机物生活基本结构Copyright2004-2015版权所有盗版必究细菌的结构示意图①②③④⑤⑥细胞壁细胞膜荚膜细胞质遗传物质鞭毛鞭毛,能帮助细菌自由移动
荚膜,有保护细菌的作用
Copyright2004-2015版权所有盗版必究4、细菌的繁殖细菌的分裂生殖示意图细菌的这种生殖方式属于,(填“有性”或“无性”)生殖
细菌是通过进行繁殖的
细胞分裂无性Copyright2004-2015版权所有盗版必究细菌的分裂生殖细菌是靠分裂进行生